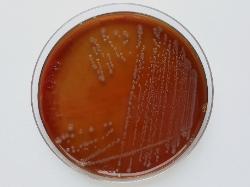

| Moraxella cuniculi |
| Moraxella cuniculi colonies on sheep blood agar |
| Moraxella cuniculi cells, Gram stainig |
Taxonomy
Morphology
Cultural characteristics
Biochemical characters
Ecology
Pathogenicity
References
Phylum Pseudomonadota (Proteobacteria), Class Gammaproteobacteria, Order Pseudomonadales, Family Moraxellaceae, Genus
Moraxella, Moraxella cuniculi (Berger 1962) Bovre and Hagen 1984.
Basonym: Neisseria cuniculi Berger 1962.
Moraxella, Moraxella cuniculi (Berger 1962) Bovre and Hagen 1984.
Basonym: Neisseria cuniculi Berger 1962.
Gram-negative diplococci, 0.6-1.0 μm. Division in two planes at right angles to each
other and tetrad formation may be observed. Non-motile.
other and tetrad formation may be observed. Non-motile.
The colonies are conical, opaque, and often friable. The colony size in 48 h is similar
to, or slightly smaller than, that of M. catarrhalis. Nonhemolytic. Aerobic. Optimum
growth temperature 37 ºC. Can grow at 42 ºC. No growth on MacConkey agar or in
minimal medium containing ammonium and acetate.
to, or slightly smaller than, that of M. catarrhalis. Nonhemolytic. Aerobic. Optimum
growth temperature 37 ºC. Can grow at 42 ºC. No growth on MacConkey agar or in
minimal medium containing ammonium and acetate.
Isolated from the mouth of healthy rabbits.
Undetermined
- Elliot Juni and Kjell Bovre. Order IX Pseudomonadales Orla-Jensen 1921, Family II Moraxellaceae Rossau, Van Landschoot,
Gillis and De Ley 1991 In: Bergey’s Manual of Systematic Bacteriology, Second edition, Vol two, part B, George M. Garrity (Editor -
in - Chief), pp. 411-442. - B. Wesley Catlin. NOTES. Branhamaceae fam. nov., a Proposed Family To Accommodate the Genera Branhamella and Moraxella.
International Journal Of Systematic Bacteriology Apr,. 1991, Vol. 41, No. 2, p. 320-323. - Veron (M.), Lenvoise-Furet (A.), Coustere (C.), Ged (C.) and Grimont (F.): Relatedness of three species of "false neisseriae",
Neisseria caviae, Neisseria cuniculi, and Neisseria ovis, by DNA-DNA hybridizations and fatty acid analysis. Int. J. Syst. Bacteriol.,
1993, 43, 210-220. - I. Vela, C. Sanchez-Porro, V. Aragon, A. Olvera, L. Domínguez, A. Ventosa, and J. F. Fernandez-Garayzabal. Moraxella porci sp.
nov., isolated from pigs. Int J Syst Evol Microbiol October 2010 60:2446-2450.
Positive results for alkaline phosphatase, acid phosphatase (weak reaction),
catalase, esterase and oxidase.
Negative results for DN-ase, gelatin liquefaction, indole production, nitrate reduction,
phenylalanine deamination, Tween 80 hydrolysis and urease. Acid is not produced
from sugars.
catalase, esterase and oxidase.
Negative results for DN-ase, gelatin liquefaction, indole production, nitrate reduction,
phenylalanine deamination, Tween 80 hydrolysis and urease. Acid is not produced
from sugars.

(c) Costin Stoica

| Antibiogram |
| Encyclopedia |
| Culture media |
| Biochemical tests |
| Stainings |
| Images |
| Movies |
| Articles |
| Identification |
| Software |
| R E G N U M PROKARYOTAE |

| Back |